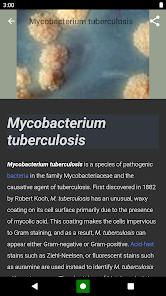

Bacteria: Types, Infections
다운로드수 31-
0 (0명)
| 분류 | 교육 |
|---|---|
| 버전 | 1.0.51.205 |
| 연령 | 3세 이상 |
| 업데이트 | 2018. 11. 28. |
| 금주 다운수 | 0 |
| 누적 다운수 | 31 |
| 개발사 | Anna Voronich |
| 다운로드 | |
|
!소프트웨어 사용범위 위반 시
법적 책임을 질 수 있습니다. |
|
상세정보
Introducing quotBacteria Types Infectionsquot the ultimate education app designed for students educators healthcare professionals researchers public health officials pharmacists and the general public seeking knowledge about bacteria and infections Unlock the world of microbiology and healthcare with our comprehensive features and resources
Comprehensive Bacteria Database Access a vast database of bacteria types and their characteristics aiding in identification and understanding
Infection Information Explore indepth information on various infectious diseases including symptoms complications and treatment options
Antibiotic Resistance Gain insights into the growing concern of antibiotic resistance and learn about responsible antibiotic use
Diagnostic Methods Discover a wide range of diagnostic methods used to identify bacterial infections enhancing your understanding of clinical assessments
Interactive Visuals Engage in interactive visuals that bring the world of bacteria to life facilitating a dynamic learning experience
Emerging Infections Stay updated with the latest information on emerging bacterial strains and outbreaks ensuring you are informed and prepared
Research Updates Access timely research updates from the field of microbiology and infectious diseases keeping you at the forefront of knowledge
Offline Access Enjoy uninterrupted learning with offline access to all resources allowing you to study anytime anywhere
UserFriendly Interface Navigate seamlessly through the app39s intuitive interface providing a userfriendly experience for all users
Bookmarking and NoteTaking Personalize your learning journey by bookmarking important sections and taking notes all available offline
Export articles to PDF Create your own comprehensive reference library by exporting articles to PDF format for easy access and sharing
Discover the power of quotBacteria Types Infectionsquot and unlock a world of knowledge From students and educators to healthcare professionals and researchers this app caters to your unique needs providing valuable insights and empowering you to make informed decisions
Key Benefits
Enhance your understanding of bacteria identification infectious diseases and microbiology concepts
Access a comprehensive bacteria database for accurate information and reference
Stay informed about antibiotic resistance and responsible antibiotic use
Learn about diagnostic methods and clinical assessments for accurate diagnosis
Visualize microscopic bacteria images through interactive visuals
Receive timely updates on emerging bacterial strains and outbreaks
Stay at the forefront of research with the latest updates
Enjoy offline access for uninterrupted learning
Personalize your learning experience with bookmarking and notetaking features
Create your own reference library by exporting articles to PDF
Download quotBacteria Types Infectionsquot now and embark on a fascinating journey through the world of bacteria and infectious diseases Gain knowledge make informed decisions and contribute to a healthier future
리뷰
- 소프트쉐어 신규 소프트웨어 추가 안내 2025.01.17
- 소프트쉐어 서비스 이용 가이드 업데이트 안내 2025.01.17
- 소프트쉐어 웹사이트 리뉴얼 안내 2025.01.17